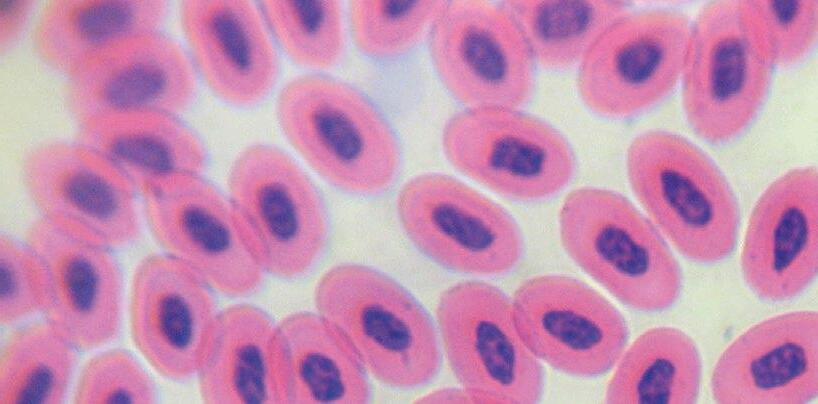

Gloria C. Ramirez-Nieto, Arlen P. Gomez, Maria Paula Urian Avila



GRUPO DE COMUNICACIÓN
AGRINEWS LLC

Luis Carrasco +34 605 09 05 13 lc@agrinews.es
Adoración Guerrero Guzmán +)34( 664 66 06 05 int@grupoagrinews.com
Nicole Carletti Ramírez +57 312 391 9330 avinewslatam@grupoagrinews.com
Mercé Soler
José Luis Valls
Osmayra Cabrera
María de los Angeles Gutiérrez Nicole Carletti Ramírez Héctor David Corredor Martínez
Edgar Oviedo Eduardo Cervantes


aviNews Legal Deposit B11597-2013


H&N Technical Team
Bill Potter
MBA, MS, PhD, Assoc. Professor, Poultry
Food Safety & Processing Extension Specialist University of Arkansas

Cobb Technical Services Team
Mabel Sibonginkosi Ndebele Poultry Production Consultant, Bulawayo, Zimbabwe

Humberto Marques Lipori
MSc. Zootechnics

Winfridus Bakker winfridus.bakker@gmail.com

Isabel M. Gimeno DVM, PhD
Professor, North Carolina State University, Zoetis Content
Edgar O. Oviedo-Rondón Prestage Department of Poultry Science, North Carolina State University. Raleigh, NC

Edgar O. Oviedo-Rondón Prestage Department of Poultry Science, North Carolina State University. Raleigh, NC

Fahad Alfayez
Project Manager for the Saudi Agriculture exhibition

Eliana Icochea D’Arrigo Avian Pathology Laboratory, Faculty of Veterinary Medicine, UNMSM-Lima-Peru

José Luis Valls García Poultry Veterinary Consultant

Gloria C. Ramirez-Nieto, Arlen P. Gomez, Maria
Paula Urian Avila Molecular Biology and Virology Laboratory, Faculty of Veterinary Medicine and Zootechnics, Universidad Nacional de Colombia















cdc.)
.)gov/one-health/about/index.html









The Chore-Time Direct-Drive Fan allows for maximum precision control of your house ventilation while saving you money. Fully compatible with your CATALYST® Controller, EnduraMax™ Fans use your existing sensors with its variable speed motor to ensure stable temperatures for better bird performance. The 57-inch (145-cm) diameter makes it easy to upgrade from your belt-driven fans.